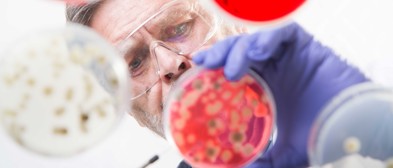
AMR
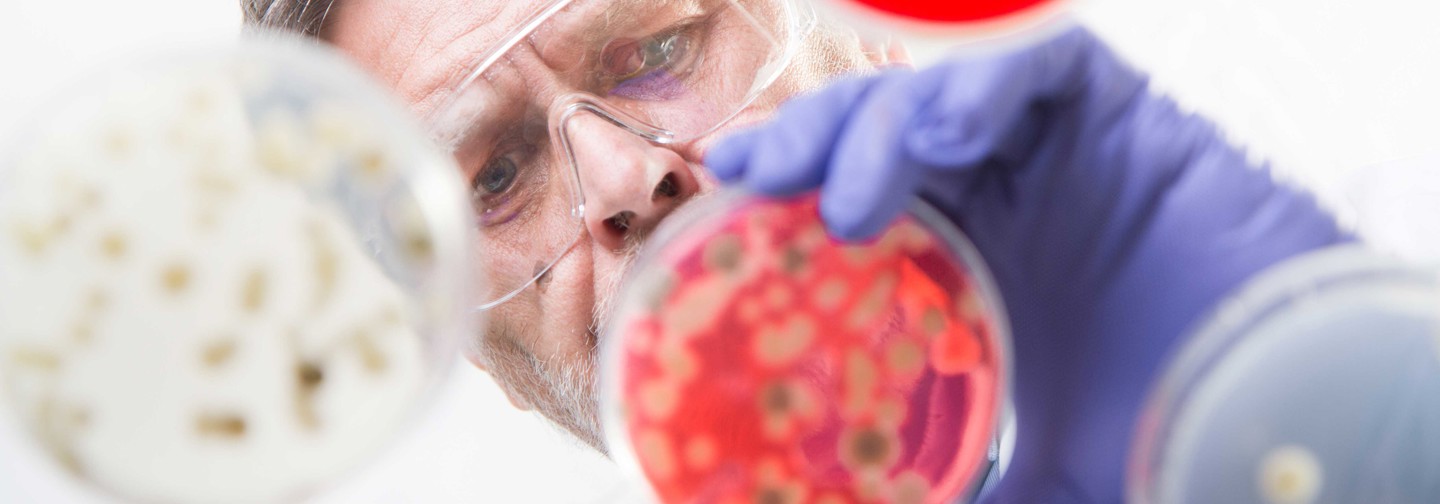
AMR

AMR
Antimicrobial resistance (AMR) is a growing threat to global health and has been acknowledged to be one among the top three major public health threats by the World Health Organization (WHO). Undermining the effectiveness of life-saving treatments and placing populations at heightened risk to infections that are increasingly difficult—or even impossible—to treat within hospital and community healthcare settings
To combat the emergence and spread of antibiotic-resistant bacteria, there is a critical need for accessible, effective, and cost-efficient solutions that promote the responsible use of antibiotics. Antimicrobial Susceptibility Testing (AST) plays a vital role in addressing this challenge, supporting the appropriate use of antibiotics, improves patient outcomes, and helps slow the emergence of resistant pathogens.
Mast Group has extensive experience in the development of antimicrobial susceptibility testing and resistance detection solutions. For many years, MAST has actively supported laboratories in tackling antimicrobial resistance by continually expanding and updating its product portfolio in response to evolving resistance mechanisms and international guidelines.
With a strong foundation in microbiology and diagnostic innovation, Mast delivers reliable solutions for both screening and confirmatory testing using a variety of technologies including colorimetric tests, combination discs and disc diffusion screening tests. These products enable laboratories to rapidly detect resistant bacteria, support timely clinical decision-making, and implement effective infection control measures to limit the spread of antimicrobial resistance.